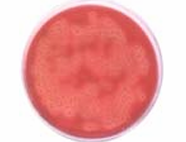

Refreshing Facial Cleanser with Niacinamide, Glycolic Acid (AHA) and Salicylic Acid (BHA)
As we celebrate our first anniversary, our Refreshing Facial Cleanser continues to shine as a bestseller across leading beauty platforms. Infused with Niacinamide and 10+ actives, it’s crafted for oily and combination skin to gently clear impurities, regulate excess oil, removes makeup and leave skin nourished, balanced, and radiant.
Volume: 100ml / 3.4 fl oz
Today's Offer
- Flat 15% Off
Key Actives
- Niacinamide (Vitamin B3)
- Salicylic Acid (BHA)
- Glycolic Acid (AHA)
- Aloe Vera
- Peppermint
- Rosemary
- Tea Tree
- Lemongrass
- Sebustop
Benefits
- Controls Excess Oil Production
- Fights Acne Causing Bacteria
- Removes Blackheads & Whiteheads
- Prevents Frequents Breakouts
- Unclogs & Shrinks Pores
- Removes Makeup & Dead Skin Cells
- Soothes Irritation & Redness
- Heals & Revives Dull Skin
- Gives Instant Refreshment
Full List Of Ingredients
Aqua, Cocamidopropyl Betaine, Decyl Glucoside, Cellulose Gum, Niacinamide, Aloe Barbadensis Leaf Extract, Glycolic Acid, Xanthan Gum, Cinnamomum Cassia Bark Extract (Cinnamon), Zingiber Officinale (Ginger) Root Extract, Sanguisorba Officinalis Root Extract, Butylene Glycol, Salicylic Acid, Mentha Piperita (Peppermint) Oil, Sodium Gluconate, Melaleuca Alternifolia (Tea Tree) Leaf Oil, Rosmarinus Officinalis (Rosemary) Leaf Oil, Propylene Glycol, Cymbopogon Citratus Extract, Phenoxyethanol, Ethylhexylglycerin, Fragrance, Sodium Hydroxide, Sodium Benzoate
Our Guarantees
- Sulphate Free
- Paraben Free
- Dyes/Colourant Free
- Plant base cleansing agent
- Anti-oxidant benefits
- Coconut surfactant

Refreshing Facial Cleanser with Niacinamide, Glycolic Acid (AHA) and Salicylic Acid (BHA)


Deep cleanse with natural actives!
Cleanse your skin naturally with the power of botanical actives. Peppermint, with its antibacterial properties, purifies the skin, while Lemongrass effectively eliminates bacteria. Aloe Vera gently exfoliates, removing dirt and impurities. Tea Tree controls excess oil, and Rosemary deeply cleanses pores.


Say goodbye to stubborn acne and breakouts
Supercharged with Salicylic Acid that penetrates deep into pores, exfoliating and dissolving excess oil. Sebustop helps kill acne-causing bacteria and reduces inflammation, while Aloe Vera soothes and hydrates irritated skin, promoting healing. Together, these ingredients work to clear breakouts, calm redness, and promote healthier skin.


Glow like never before!
Reduce dark spots and get a glowing and even complexion with Glycolic Acid and Niacinamide. Glycolic Acid aka AHA highly promotes cell turn over which helps reduce stubborn dark spots and pigmentation. In addition, Niacinamide aka Vitamin B3 inhibits transfer of melanin to the skin cells, therefore brightening skin's complexion.
If you have any questions, you are always welcome to contact us. We'll get back to you as soon as possible, within 24 hours on weekdays.
Shipping Information
Use this text to answer questions in as much detail as possible for your customers.
Customer Support
Use this text to answer questions in as much detail as possible for your customers.
FAQ’s
Use this text to answer questions in as much detail as possible for your customers.
Contact Us
Use this text to answer questions in as much detail as possible for your customers.


How to use for optimal results
STEP 1: CLEANSE 💦
Start your skincare with our Refreshing Facial Cleanser with AHA and BHA to remove any dirt, oil, or makeup.
- Begin by gently shaking the bottle to ensure all the ingredients are evenly mixed, activating the formula for maximum efficacy.
- Thoroughly wet your face and neck with lukewarm water, ensuring your skin is completely damp. This helps the cleanser glide smoothly and penetrate effectively.
- Pump out two generous pumps of the cleanser onto your palm. Spread it evenly across your hands, allowing for a smooth and even application.
- Using your palms, apply the cleanser evenly to your face, ensuring every area is covered—from your forehead to your neck.
- With gentle, circular motions, massage the cleanser into your skin—massaging thoroughly allows the cleanser to work deeper into your pores, leaving your skin refreshed and clean.
- Rinse your face and neck thoroughly with lukewarm water to remove all traces of the cleanser. Pat your skin dry with a soft towel, avoiding any harsh rubbing.
STEP 2: TREAT
Follow Step 1 with our Rejuvenating Serum for amazing results in no time.
NOTE: USE DAY☀️ + NIGHT🌙
Our Cleanser gives best results when used twice daily.
Acne Reduction Result

BEFORE

Within 2 weeks* of application
AFTER
Similar results are visible after regular usage of the Cleanser (twice a day for 2-4 weeks). However, the results might vary depending on the intensity of acne and from individual to individual.
Bacteria Control Result
BEFORE

Observation after 72h* of growth of Propionibacterium acnes
AFTER
The images are picked from clinical testing and might not be of highest resolution, but are digitally scanned using advance tools and techniques to show real results. However, the results might differ from individual to individual.

Good to know facts about our Refreshing Cleanser
💛 Our cleanser has a no artificial fragrance, it is infused with peppermint which is a natural active to give you that instant refreshment.
💛 It is a transparent cleanser with a very slight tinge of yellow imparted by vitamin c extracts (barely recognisable with the naked eye).
💛 Our outer packaging is sustainable and is reusable. Click here and here to see some creative ways of reusing our packaging.
💛 We use reusable glass bottles to preserve the potency of our ingredients, as plastic can compromise their effectiveness.
💛 We use a pump vs a tube dispenser for our Cleanser to avoid it being contaminated or being exposed to air, thereby retaining its efficacy and potency right till the last drop.
💛 In just a year, our Refreshing Cleanser has become a bestseller across leading beauty platforms, loved for its efficacy and refreshing experience.
Also Available At
FAQs
What are the benefits of using Refreshing Facial Cleanser?
- Reduces acne and frequent breakouts
- Unclogs and minimises appearance of large pores
- Hydrates and soothes skin
- Gives instant refreshment and glow
- Removes blackheads and whiteheads
- Controls excess oil production
When should I use the cleanser?
The cleanser is recommended to be used as the first step in your skincare routine. This helps remove all the dirt, oil and makeup, preparing your skin for better absorption of the serum and following products.
I have normal to dry skin, can I still use the Refreshing Facial Cleanser?
Yes! Our Cleanser is formulated to cater to oily, combination and normal skin type. The Cleanser ensures to control excess oil production without ripping it off its natural and essential oils.
How long will one bottle last?
One bottle typically lasts 8 weeks, depending on how much you use per application.